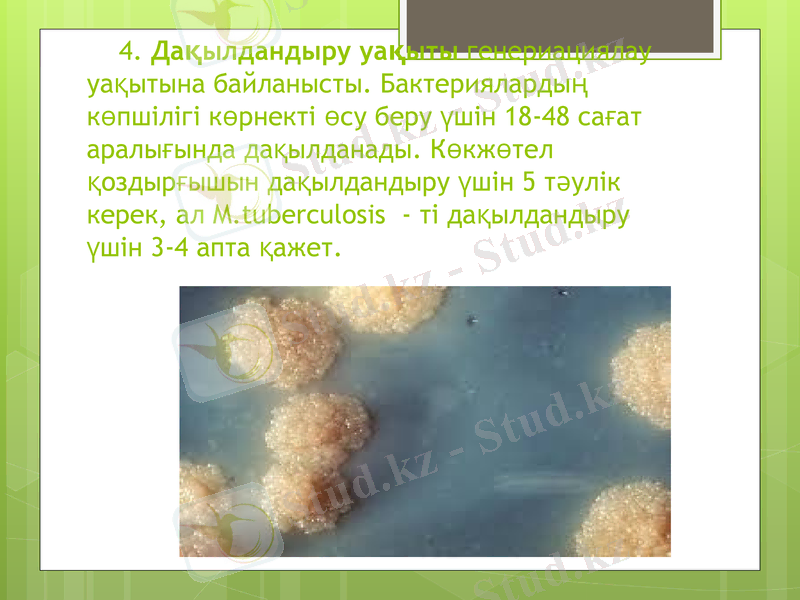
Slide 33

Аэробтық және анаэробтық бактерияларды ажырату мен таза дақылын бөліп алу сатылары



Қазақстан Республикасының Денсаулық Сақтау және әлеуметтік даму Министрлігі
к Фармацевтикалық АкадеФармакагнозия және химия кафедрасы
Презентация
Орындаған: Бегмаганбетов Д.
Тобы:207 А
Тақырыбы: Аэроб және анаэроб бактериалардың ажырату және таза дақылын бөліп алу сатылары.
«ҚАЗАҚСТАН-РЕСЕЙ
МЕДИЦИНАЛЫҚ УНИВЕРСИТЕТІ» МЕББМ
НУО «КАЗАХСТАНСКО-РОССИЙСКИЙ
МЕДИЦИНСКИЙ УНИВЕРСИТЕТ»

Жоспар
І Кіріспе
ІІ Негізгі бөлім
1. Тыныс алу түрлері.
2. Аэроб және анаэробқа толық сипаттама
3. Аэроб және анаэроб бактериалардың ажырату және таза дақылын бөліп алу сатылары.
ІІІ Қорытынды
Пайдаланылған әдебиеттер

Кіріспе
Бұл тақырыпта организмдердің тыныс алу жолдары жайлы тоқталамын, жалпы тыныс алу жолдары туралы ілімді ашқан ғалымдар - М. В. Ломоносов (1757) және А. Л. Лавуазье (1777) болып саналады. Ал тыныс алудың түрлерін химияның атасы ретінде аталатын 1861 жылы Л. Пастер ашқан, ол май қышқылын ашытатын бактерияны тапқаннан кейін анаэробты организмдер терминін ғылымға енгізген. Кейіннен тыныс алу жолдары 3 топқа жіктелді: аэробты, анаэробты және факультативті осы ұғымдар жайлы кеңінен тоқталамыз.

Тыныс алу түрлері Тыныс алу туралы ілімнің негізін қалаушылар - М. В. Ломоносов (1757) және А. Л. Лавуазье (1777) болып саналады.

Оттектің қатысында органикалық заттардың жануы табиғатта жүрсе, ал тірі организмдердегі тыныс алу процестері митохондрия органоидында жүзеге асады.

Жану кезіндегі энергия жылу түрінде бөлінсе, ал тыныс алу кезіндегі бөлініп шыққан энергия организмдердің бүкіл тіршілік процестеріне және өзінің құрылымын белсенді күйде сақтауға жұмсалады. C6H12O6 + 6O2 = 6CO2 + 6H2O + 2881 кДж/моль.

Тыныс алу түріне қарай микроағзалар :


Аэробты бактериялар екі топқа бөлінеді:


лептоспиралар


1861 жылы Л. Пастер өзіндік ерекшелігі бар анаэроб бактериялрды тапқан болатын.

Аэробтық организмдер Аэробтар (гр. αηρ - ауа және βιοζ - тіршілік) - молекулалық бос оттек (О2) бар ортада тіршілік етіп, дами алатын организмдер. Аэробтық организмдерге барлық өсімдіктер, көптеген қарапайымдылар мен көп клеткалы жануарлар, саңырауқұлақтар, микроорганизмдер жатады.


Оттектің (О2) қатысуымен жүретін биологиялық процесті аэробиоз деп атайды. Аэробтық организмдер өз организміне енген О2-нің тотығуынан пайда болған энергияны пайдаланады.

Аэробтық организмдердің арасында ең маңыздысы фотосинтез процесіне қатысатын организмдер - цианобактериялар, балдырлар және түтікті өсімдіктер.

Аэробтық организмдер табиғатта кеңінен таралған және ондағы зат айналымына үлкен әсерін тигізеді, мысалы, қарапайым аэробтық организмдер топырақтағы күрделі органикалық қосылыстарды өсімдіктердің жақсы сіңіруіне көмектесіп, топырақтағы түрлі ауру қоздыратын бактерияларды жояды. Аэробтық организмдерді өндірісте сірке суын алуға, ауыл шаруашылығында, т. б. қолданылады. Аэробтық организмдердің тіршілігіне ауаның құрамындағы оттектің белгілі мөлшері мен қысымы қажет, егер осы жағдай шамадан тыс өзгерсе, олар өліп қалады.


Гликолиздің оттекті (аэробты) ыдырауы. оттектің қатысымен глюкоза толық ыдырап, соңғы өнім ретінде CO2 және H2O түзіледі. Реакцияның бастапқы заты ретінде 2 моль C3H6O3 (сүт қышқылы) қатысады. Нәтижесінде 36 моль АТФ синтезделеді.

Гликолиздің оттекті (аэробты) ыдырауы. оттектің қатысымен глюкоза толық ыдырап, соңғы өнім ретінде CO2 және H2O түзіледі. Реакцияның бастапқы заты ретінде 2 моль C3H6O3 (сүт қышқылы) қатысады. Нәтижесінде 36 моль АТФ синтезделеді.

Анаэробты организмдер Анаэробтар (гр. an - сыз, сіз, емес қосымшасы, гр. aеer - ауа және гр. bіos - тіршілік) - оттексіз ортада өсіп-өніп, тіршілік ететін организмдер. 1861 жылы Л. Пастер май қышқылын ашытатын бактерияны тапқаннан кейін анаэробты организмдер терминін ғылымға енгізген. Анаэробты организмдер негізінен прокариотты организмдер арасында кең тараған.

Ал эукариотты организмдер арасында ашытқы саңырауқұлақтарында, буынаяқтылардың ішегінде өмір сүретін қарапайымдарда, ал көп клеткалы организмдер ішінде ішек паразиттерінде (атап айтқанда таспа құрттар мен аскаридаларда) кездеседі.

Анаэробты организмдер тіршілік ететін ортасында оттектің болу не болмауына байланысты :
факультативті анаэробты организмдер
облигатты анаэробты организмдер

Олигатты анаэробты организмдер - тіршілігі мүлдем оттексіз жүретін организмдер. Оларға май қышқылы бактериясы және сіреспе бактериялары жатады. Көп клеткалы жануарлар арасында олигатты анаэробты организмдер кездеспейді.
Факультативті анаэробты организмдер - табиғатта оттектің бар-жоғына қарамай тіршілік ететін организмдер (мысалы, ашытқы саңырауқұлақтары, іш сүзегі, топалаң қоздырғыштары, т. б. ) .

олигатты анаэроб
факультативті анаэроб

Аэроб және анаэроб бактериалардың ажырату және таза дақылын бөліп алу сатылары. Бактериаларды дақылдандыру үшін бірқатар шарттарды сақтау қажет. 1. Құнды коректік ортаның болуы. Кез-келген орта құрамының күрделілігі мен пайдалану мақсатына қарамастан негізі судан, энергия мен көмірсутегінің органикалық көзінен, тұрақты рН пен осмостық қысымға ие болуы қажет.

2. Дақылдандыру температурасы. Көбею жылдамдығына температура әсерін тигізеді. Температураға бактериялар әрә түрлі жауап береді:

3. Дақылдандыру атмосферасы. Қатаң аэробтар өсіп көбеюі үшін оттегі қажет. Аэробтар Петри таяқшасындағы агардың бетінде немесе сұйық ортаның жұқа беткі қабатында жақсы өседі. Қатаң аэробтардың сұйық ортаның терең деңгейлерінде өсуін қамтамасыз ету үшін оттегі бүкіл қоректік ортаға диффузды түрде таралуы қажет. Бұған қоректік ортаның үздіксіз аралатырып немесе сілкіп отыру, атап айтқанда аэрациялау арқылы қол жеткізеді. Аэрациялау арнайы аппараттармен -сілкілігішпен іске асырылады.


Факультативті анаэробтарды дақылдандыру үшін жоғарыда аталып кеткен әдістерді қолданады, себебі оттегі бар жерде оларға энергетикалық қамтамасыз етуде оксидативті метаболизм ферментациядан тиімді болады. Микроаэрофилдер оттегінің парциалдық қысымы төмен жағдайда көбейеді. Бұған ауадағы СО2-нің парциалдық қысымы 0, 03 %- ға қарағанда дақылдандыру атмосферасындағы СО2 парциалдық қысымын 1-5% концентрациясына көтеру арқылы қол жеткізіледі. Бұл үшін арнайы СО2 инкубаторлар қолданылады немесе себінділерді жанып тұрған шырағдан қойылған эксикаторларға орналастырады.

3. Облигатты анаэробтар өсу және көбею үшін ауадағы оттегінің ортаға түспеуін талап етеді. Бұған келесі шаралар арқылы қол жеткізіледі:
- Іс жүргізу
- Автоматтандыру, Техника
- Алғашқы әскери дайындық
- Астрономия
- Ауыл шаруашылығы
- Банк ісі
- Бизнесті бағалау
- Биология
- Бухгалтерлік іс
- Валеология
- Ветеринария
- География
- Геология, Геофизика, Геодезия
- Дін
- Ет, сүт, шарап өнімдері
- Жалпы тарих
- Жер кадастрі, Жылжымайтын мүлік
- Журналистика
- Информатика
- Кеден ісі
- Маркетинг
- Математика, Геометрия
- Медицина
- Мемлекеттік басқару
- Менеджмент
- Мұнай, Газ
- Мұрағат ісі
- Мәдениеттану
- ОБЖ (Основы безопасности жизнедеятельности)
- Педагогика
- Полиграфия
- Психология
- Салық
- Саясаттану
- Сақтандыру
- Сертификаттау, стандарттау
- Социология, Демография
- Спорт
- Статистика
- Тілтану, Филология
- Тарихи тұлғалар
- Тау-кен ісі
- Транспорт
- Туризм
- Физика
- Философия
- Халықаралық қатынастар
- Химия
- Экология, Қоршаған ортаны қорғау
- Экономика
- Экономикалық география
- Электротехника
- Қазақстан тарихы
- Қаржы
- Құрылыс
- Құқық, Криминалистика
- Әдебиет
- Өнер, музыка
- Өнеркәсіп, Өндіріс
Қазақ тілінде жазылған рефераттар, курстық жұмыстар, дипломдық жұмыстар бойынша біздің қор #1 болып табылады.



Ақпарат
Қосымша
Email: info@stud.kz